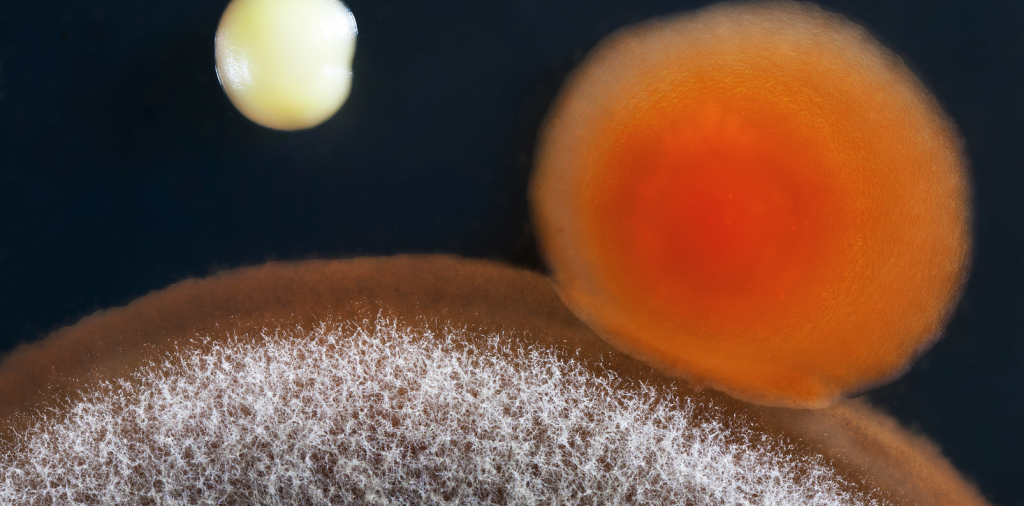
mold-toxicity

Scleroderma

Demystifying Scleroderma: Gundry Health’s Comprehensive Approach to Autoimmune Disease Management Scleroderma, also known as systemic sclerosis, is a complex autoimmune disease that can significantly impact an individual’s life. This article aims to provide a comprehensive understanding of scleroderma and how Gundry Health is helping manage this condition. Scleroderma is a long-lasting disease that affects the […]
Susac’s Syndrome

A Comprehensive Guide to Susac’s Syndrome and Personalized Treatment Options – Gundry Health Susac’s Syndrome is a rare autoimmune disorder that affects the very small blood vessels in the brain, retina, and inner ear1. It is characterized by a clinical triad of encephalopathy, branch retinal artery occlusions (BRAO), and hearing loss2. The exact cause of […]
Understanding Mold Toxicity
Understanding Mold Toxicity Exposure to environmental toxins, particularly mycotoxins from moldy conditions, poses a significant risk to overall health. Mold toxicity, often overlooked or misattributed, can manifest in various symptoms, ranging from respiratory issues to neurological problems. Identifying Mold Exposure Determining whether symptoms stem from mold exposure can be challenging. Recognizing warning signs and understanding […]
Understanding Gluten Intolerance

Understanding Gluten Intolerance Gluten, a protein found in wheat, barley, malt, and rye, is pervasive in many food products, including pasta, bread, cereal, and baked goods. Despite its prevalence, gluten can trigger adverse reactions in individuals with sensitivities or allergies. Understanding the symptoms and effects of gluten intolerance is crucial for managing one’s health. The […]
All You Need To Know About Magnesium Glycinate

All You Need To Know About Magnesium Glycinate Magnesium glycinate is a popular supplement known for its effectiveness in boosting magnesium levels in individuals with deficiencies. It is particularly favored for its high absorption rate and minimal side effects compared to other forms of magnesium supplements. What is Magnesium Glycinate? In the realm of magnesium […]
Vitiligo

Vitiligo – Causes, Symptoms, Treatment, and Support Vitiligo is a medical condition in which patches of skin lose their color, resulting in white patches on the skin12. This condition can be life-altering, as patients may struggle with self-esteem or depression and often have to deal with social stigma due to misunderstanding about the contagiousness of […]
Vasculitis

Vasculitis Causes, Symptoms, and Management Strategies Vasculitis is a group of rare diseases that cause inflammation of the blood vessels, arteries, veins, or capillaries. 1 This blog aims to shed light on this condition, its causes, symptoms, types, and how it can be managed effectively. What is Vasculitis? Vasculitis occurs when the body’s immune system […]
Undifferentiated Connective Tissue Disease

Undifferentiated Connective Tissue Disease – UCTD: A Comprehensive Overview Undifferentiated Connective Tissue Disease (UCTD) is a relatively rare autoimmune disorder that often leaves patients and healthcare professionals alike puzzled due to its complex nature. This article aims to shed light on UCTD, its symptoms, causes, and available treatments. What is Undifferentiated Connective Tissue Disease? UCTD […]
Ulcerative Colitis

Ulcerative Colitis – Symptoms, Risk Factors, and Gundry Health’s Treatment Approach Ulcerative colitis (UC), a type of inflammatory bowel disease, is a long-term condition that affects the colon and rectum. This article aims to provide a comprehensive understanding of UC, its symptoms, risk factors, and the treatment approach offered by Gundry Health, an online clinical […]
Thyroid Eye Disease

Thyroid Eye Disease A Comprehensive Guide to TED Thyroid Eye Disease (TED), also known as Graves’ Ophthalmopathy, is a complex and potentially serious condition that affects the eyes and surrounding tissues 1. It is characterized by inflammation and damage to the tissues around the eye, including muscles, fatty tissue, and connective tissue. The disorder is […]